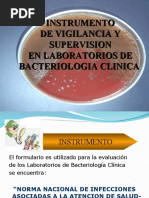

100% encontró este documento útil (1 voto)
447 vistas13 páginasNorma Iso 15189
La Norma ISO 15189 establece los requisitos para los sistemas de gestión de calidad de los laboratorios clínicos. Se divide en requisitos de gestión y técnicos. Exige personal cualificado, equipos adecuados, y procesos de control de calidad. Su objetivo es demostrar la competencia técnica de los laboratorios y la validez de sus resultados para asegurar la calidad y seguridad en los análisis clínicos.
Cargado por
danielDerechos de autor
© © All Rights Reserved
Nos tomamos en serio los derechos de los contenidos. Si sospechas que se trata de tu contenido, reclámalo aquí.
Formatos disponibles
Descarga como PDF, TXT o lee en línea desde Scribd
100% encontró este documento útil (1 voto)
447 vistas13 páginasNorma Iso 15189
La Norma ISO 15189 establece los requisitos para los sistemas de gestión de calidad de los laboratorios clínicos. Se divide en requisitos de gestión y técnicos. Exige personal cualificado, equipos adecuados, y procesos de control de calidad. Su objetivo es demostrar la competencia técnica de los laboratorios y la validez de sus resultados para asegurar la calidad y seguridad en los análisis clínicos.
Cargado por
danielDerechos de autor
© © All Rights Reserved
Nos tomamos en serio los derechos de los contenidos. Si sospechas que se trata de tu contenido, reclámalo aquí.
Formatos disponibles
Descarga como PDF, TXT o lee en línea desde Scribd